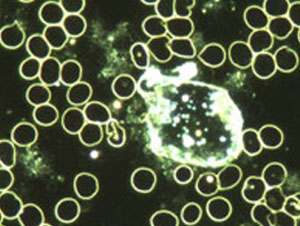
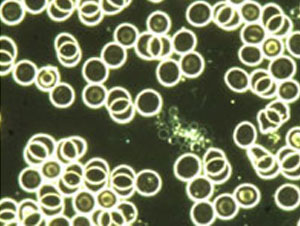
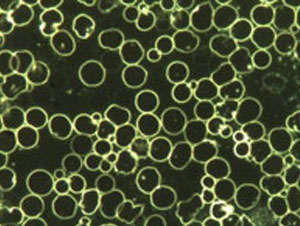

Dunkelfeldmikroskopie, Säure-Messung
Dunkelfeldmikroskopie
Die Untersuchung des lebenden Blutes im Dunkelfeldmikroskop ist eine wichtige ganzheitliche Blutuntersuchung. Sie gibt Aufschluss über das innere Milieu und die Funktionsfähigkeit der Blutzellen. Bei der Dunkelfeldmikroskopie ist es möglich, Belastungen im lebenden Blut zu sehen, die zu chronischen Erkrankungen führen können. Beim sonst üblichen, normalen Labor werden in der Regel die Bestandteile gezählt, jedoch nicht in ihrer Funktion erfasst. Auch wird das Blut sonst abgetötet mit Zusätzen, Hitze oder Farbstoffen.
Für den Patienten ist die Dunkelfelduntersuchung einfach: Etwas Blut aus der Fingerkuppe genügt dem Arzt, der es direkt auf den Objektträger eines dafür speziell eingerichteten Mikroskops gibt und (ohne Färbung!) mit einer 1000-fachen (!) Vergrösserung untersucht. Der erste Blick ins Mikroskop gibt Aufschluss über den Säure-Basen-Haushalt und die Eiweisskonsistenz im gesamten Organismus. Aber auch Belastungen der Leber, der Nieren und des Darmes sind für den Fachmann sofort erkennbar. Besonders bemerkenswert ist aber die Möglichkeit, den Zustand des Immunsystems sofort beurteilen zu können.

Dunkelfeldmikroskopie
Die Untersuchung des lebenden Blutes im Dunkelfeldmikroskop ist eine wichtige ganzheitliche Blutuntersuchung. Sie gibt Aufschluss über das innere Milieu und die Funktionsfähigkeit der Blutzellen. Bei der Dunkelfeldmikroskopie ist es möglich, Belastungen im lebenden Blut zu sehen, die zu chronischen Erkrankungen führen können. Beim sonst üblichen, normalen Labor werden in der Regel die Bestandteile gezählt, jedoch nicht in ihrer Funktion erfasst. Auch wird das Blut sonst abgetötet mit Zusätzen, Hitze oder Farbstoffen.
Für den Patienten ist die Dunkelfelduntersuchung einfach: Etwas Blut aus der Fingerkuppe genügt dem Arzt, der es direkt auf den Objektträger eines dafür speziell eingerichteten Mikroskops gibt und (ohne Färbung!) mit einer 1000-fachen (!) Vergrösserung untersucht. Der erste Blick ins Mikroskop gibt Aufschluss über den Säure-Basen-Haushalt und die Eiweisskonsistenz im gesamten Organismus. Aber auch Belastungen der Leber, der Nieren und des Darmes sind für den Fachmann sofort erkennbar. Besonders bemerkenswert ist aber die Möglichkeit, den Zustand des Immunsystems sofort beurteilen zu können.
Säure-Basen-Messung im Blut
Ein wichtiges Regulationssystem im menschlichen Körper ist der Säure-Basen-Haushalt. Er hält das Verhältnis von Säuren und Basen im Körper mit Hilfe verschiedener Stoffwechselvorgänge konstant. Die Messgrösse für den Säure-Basen-Haushalt ist der pH-Wert, der in den verschiedenen Organen und Körperflüssigkeiten wie Blut, Lymphe, Speichel oder Urin sehr unterschiedlich ist.
Im Magen herrscht im nüchternen Zustand zum Beispiel ein pH-Wert von 1 bis 2, damit die Nahrung und insbesondere das Eiweiss aufgespaltet werden können. Im Dünndarm liegt der pH-Wert bei 5 bis 6, so dass hier Enzyme zur Kohlenhydratverdauung aktiv werden können. Im Vergleich dazu ist der pH-Wert in den meisten Körperzellen bei etwa 7 und im Blut bei 7,4; pH-Werte unter 7 gelten dabei eher als sauer, pH-Werte über 7,4 eher als basisch. In verschiedenen Körperflüssigkeiten wie dem Blut muss der pH-Wert konstant gehalten werden, kleinste Verschiebungen können den Stoffwechsel schwer beeinträchtigen und den Körper belasten.
Check-up und Vorsorge
Verantwortung für die eigene Gesundheit zu übernehmen ist ein Gebot der Vernunft – und auch der Sicherung Ihrer persönlichen Lebensqualität. Denn Gesundheit ist Ihr wichtigstes Kapital in Privat- und Berufsleben. Unser medizinisches System ist hochentwickelt, wenn es um die Behandlung akuter Krankheiten geht. Für Ihre Gesundheit sind Sie jedoch selbst verantwortlich! Um Ihren Körper optimal zu unterstützen, müssen Sie aber wissen, wo seine Schwächen sind.
Jeder Mensch ist einzigartig. Diese Einzigartigkeit zu erfassen und daraufhin optimierte Strategien zur Vermeidung von gesundheitlichen Risiken und Unterstützung Ihrer persönlichen Gesundheit zu entwickeln ist die Anforderung an einen sinnvollen und aussagekräftigen check-up. Bei gezielter Früherkennung kann man rechtzeitig aktiv werden und bereits im frühen Stadium eine Behandlung einleiten, Risikofaktoren vermeiden und abbauen. In unserer Praxis gibt es verschiedene check-ups – vom einfachen Blutbild bis zum top check-up. Individuell wird mit Ihnen das notwendige und für Sie richtige check-up-Programm ermittelt.
Haar-Mineral-Analyse
Die Haar-Mineral-Analyse ist ein Indikator Ihres biochemischen Profils und deckt Mangelzustände und Überschüsse von Mineralien und Spurenelementen auf. Die Haar-Mineral-Analyse dient zur Früherkennung von chronischen Belastungen durch Schwermetalle und andere toxische Metalle. Die Haar-Mineral-Analyse ist eine von der Weltgesundheitsorganisation (WHO) anerkannte Untersuchungsmethode.
Untersuchungen der Darmflora
Die Hauptaufgabe des Darmes liegt in der Aufnahme von Nahrungsspaltprodukten. Die Darmschleimhaut hat, wie die Haut, aber auch eine Barrierefunktion zu erfüllen, um ein Eindringen von grossmolekularen Nahrungsbestandteilen und Mikroorganismen ins Körperinnere zu verhindern. Bei einem erwachsenen Menschen wird durch Auffaltung der Darmschleimhaut eine Gesamtfläche von 150–200 m2 erreicht. Der Darm ist durch ca. 1014 verschiedene Keime besiedelt, die sich in mehr als 400 Arten und Unterarten unterteilen lassen.
Die Zahl der Mikroorganismen (=Keime) im Darm übertrifft damit die Zahl der Körperzellen um das Zehnfache. Sie verfügen über ein höheres Gewicht und eine größere Stoffwechselkapazität als die menschliche Leber. Ruft man sich diese Zahlen ins Gedächtnis, wird klar, dass sowohl Veränderungen der Darmschleimhaut als auch Störungen innerhalb der Mikroflora das physiologische Gleichgewicht des Menschen tiefgreifend beeinträchtigen können. Die Besiedlung mit Keimen in den einzelnen Abschnitten im Verdauungstrakt ist sehr unterschiedlich.
Allergie/Unverträglichkeit
Es gibt viele verschiedenen Formen von Allergien, diese werden durch verschiedene Immunglobuline (Bestandteile im Blut)(=Ig) vermittelt. Je nach beteiligten Stoffen und Immunglobulinen gibt es verschiedene Arten von Allergien oder Unverträglichkeiten.
Nahrungsmittelunverträglichkeiten gehören zu den am häufigsten von Patienten beklagten Beschwerden. Bei Inhalationsallergien kommt es häufig zu Kreuzreaktionen mit Nahrungsmittelallergien (pollenassoziierte Nahrungsmittelallergien). Insbesondere Allergien gegenüber Frischobst, Gemüse, Nüssen und Gewürzen sind mit Pollenallergien assoziiert. Unerkannte Schimmelpilzallergien sind enorm häufig. Pseudoallergische Reaktionen sind Entzündungsreaktionen, die auf der Freisetzung von Entzündungsbotenstoffen wie Histamin beruhen. Auslöser können Nahrungsmittelfarb- und -zusatzstoffe, Arzneimittelhilfsstoffe, Medikamente und natürliche Nahrungsmittelinhaltsstoffe sein. Unter einer Histaminose versteht man ein Missverhältnis zwischen dem Auftreten von Histamin und der Kapazität des Organismus zum Abbau des anfallenden Histamins. Gluten (Kleber, Klebereiweiß) ist der Oberbegriff für eine Gruppe von Proteinen, die in Getreiden vorkommen. Auch Kohlenhydratunverträglichkeiten sind sehr verbreitet.
Schwermetalle/Amalgam
Neben der Aufnahme von Schwermetallen aus der Nahrung werden auch heute immer noch Zähne mit Amalgamfüllungen repariert. Dieses Amalgam enthält zu einem grossen Teil Quecksilber, was für den Körper sehr giftig ist. Es wirkt antibakteriell, d.h. es tötet Bakterien in der Mundschleimhaut und vor allem im Darm. Daraus entsteht eine gestörte Darmflora, welche den «schlechten» Bakterien den Nährboden zum Überleben gibt. Auch Pilze wie Candida können sich so leicht entfalten.
Nicht jeder Mensch reagiert jedoch auf Schwermetalle gleich. Viele Menschen haben im Körper genügend Stoffe, die z. B. Quecksilber binden und ausschwemmen. Dadurch kommen diese Leute mit geringeren Schäden davon und haben keine Beschwerden.
DLT (Dry Layer Test)
Dieser Test ermöglicht es festzustellen, in welcher Körperregion eine Störung besteht und wie gross ihre Bedeutung für die Gesundheit des Gesamtkörpers ist.
Der Dried Layer Test basiert darauf, dass ein Bluttropfen nicht einfach eintrocknet, sondern dass dabei ganz bestimmte Strukturen entstehen. Die mikroskopische Betrachtung dieser Strukturen erlaubt es uns, im ganzheitsmedizinischen Sinne Hinweise zum Krankheitsgeschehen zu erhalten.
Dieser Test wird auch Blut-Kristallisationstest genannt: Ein Bluttropfen wird auf einer Fingerkuppe während ca. einer Minute antrocknen gelassen. In dieser Zeit findet in dem Tropfen eine Organisation statt. Nach der Antrocknungszeit werden von diesem einen Bluttropfen auf einer Glasplatte acht Abdrücke genommen.
